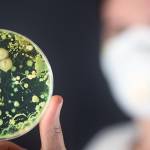

Предастмой называют состояние, которое может трансформироваться в бронхиальную астму – поражение бронхов с нарушением их проходимости и периодически возникающими приступами удушья.
Симптомы предастмы очень вариабельные, так как вариабельные причины ее возникновения. Это нарушения со стороны бронхов (кашель, одышка), глаз (слезотечение), носовой полости (выделения) и так далее.
Диагноз ставят благодаря комплексному обследованию. Иногда, чтобы исключить или подтвердить диагноз, приходится привлекать целый комплекс инструментального и лабораторного исследования, который несколькими методами не ограничивается.
Терапия – практически та же, что и при бронхиальной астме. Эффективным является лечение с помощью бронхолитиков и десенсибилизирующих препаратов.
Предастма: что это такое?
Предастма – явление довольно распространенное. Она не всегда трансформируется в астму, из-за чего заболеваемость той ниже. На самом деле предастма различной степени выраженности встречается у каждого десятого (по другим данным – каждого двадцатого) жителя популяции.
Систематизация предастматических состояний претерпевает изменения и уточнения до сих пор. Это приводит к некоторой путанице во время диагностического и лечебного процесса.
Проявления предастмы, как и астматического состояния, могут обнаруживаться практически в любой возрастной категории – от детей до людей преклонного возраста. Но чаще всего данное нарушение наблюдается в молодом и среднем трудоспособном возрасте. В последние десять лет эта патология «помолодела» – она встречается в возрастной категории 20-30 лет чаще, чем в категории 30-40 лет.
Предастма «оккупирует» все регионы земного шара. Несколько выше заболеваемость в Европе, Северной Америке и некоторых странах Африки. При этом независимо от страны проживания жители больших мегаполисов заболевают чаще и страдают более выражено, чем жители сельской местности.
Обратите внимание
В промышленных регионах, а также в местности с нарушенной экологической обстановкой предастму выявляют чаще.
Представители мужского и женского пола страдают с приблизительно одинаковой частотой, но в некоторых регионах наблюдается разница в их заболеваемости. Это связано с превалированием определенных причинных факторов, действие которых на мужчин и женщин может отличаться.
Врачи обращают внимание на то, что предастма является важным предвестником развития бронхиальной астмы. Исследования показывают, что пациенты с хроническим кашлем, свистящим дыханием и частыми респираторными инфекциями находятся в группе риска. Специалисты подчеркивают, что ранняя диагностика и лечение предастмы могут значительно снизить вероятность прогрессирования заболевания. Важно учитывать генетическую предрасположенность, а также воздействие аллергенов и загрязнителей окружающей среды. Врачи рекомендуют регулярные обследования и мониторинг состояния дыхательных путей, чтобы своевременно выявить изменения и принять необходимые меры. Профилактика и грамотное управление симптомами могут помочь избежать серьезных осложнений в будущем.

Причины
Описываемое заболевание относится к категории тех, которые могут быть вызваны десятками причинами. Они относятся к различным категориям, поэтому для удобства систематизации их разделяют на группы. Чаще всего наблюдаются такие причины, как:
- инфекционные;
- соматические;
- иммунные;
- климатические;
- бытовые;
- гормональные;
- профессиональные;
- вредные привычки;
- наследственно-генетические.
Толчком для развития предастмы может стать любой инфекционный агент:
- специфический – тот, который способен спровоцировать развитие целого ряда инфекционных патологий;
- неспецифический – тот, от наличия которого зависит развитие только какой-то одной инфекционной болезни.
Некоторые патологии респираторной (дыхательной) системы могут повышать риск возникновения предастматического состояния. Чаще всего таким фоновым заболеванием становится обструктивный бронхит – воспалительное поражение слизистой оболочки бронхов, при котором их проходимость нарушается.
Предастму могут вызвать нарушения реактивности организма – иммунные патологии. Также к этой категории причин относят аллергические реакции – в первую очередь, связанные с приемом лекарственных препаратов, а также реакции на токсины инфекционного возбудителя. В равной мере это аллергический ответ как местный (аллергический конъюнктивит – воспалительное поражение конъюнктивы, имеющее аллергическую природу), так и системный (крапивница – аллергическая сыпь в виде пузырьков, похожих на те, которые возникают при раздражении крапивой).
Обратите внимание
Фактором, вызывающим предастматическое состояние, может оказаться определенный климат, а также смена пребывания в разных климатических поясах.
Из бытовых факторов одними из наиболее весомых причин возникновения описываемого состояния являются бытовая пыль и шерсть домашних животных. Если ранее аллергия возникала чаще всего на шерсть кошек, то на данный момент контакт практически со всеми разновидностями домашних питомцев способен привести к возникновению аллергического ответа и развитию предастматического состояния.
У половины пациентов с предастмой выявляли гормональные сдвиги (в некоторых регионах – у трех пациентов из четырех). Как правило, это были:
- нарушения со стороны гормонов щитовидной железы – гипотиреоз (уменьшение их количества), гипертиреоз (увеличение количества тиреоидных гормонов);
- сахарный диабет – нарушение метаболизма (обмена) углеводов, которое возникает на фоне дефицита инсулина (гормона поджелудочной железы);
- нарушения со стороны гормонов коры надпочечников, которые возникают на фоне ее патологии (воспаления, новообразований и так далее);
- патологии женских половых гормонов.
У людей, работающих на вредном производстве, частота возникновения предастматического состояния в несколько раз выше – особенно при трудоустройстве на:
- предприятиях химической промышленности, на которых изготавливают винилхлорид, бензол, толуол и некоторые другие соединения;
- предприятиях, добывающих и перерабатывающих асбест, кремний, уголь.
Из вредных привычек наиболее весомой причиной развития предастмы является курение. Замечено, что если пациент при воздействии других причин, вызывающих развитие предастмы, курит, то это увеличивает риск возникновения у него описываемого заболевания в несколько раз. Причины такой корреляции изучаются. Также всплеск заболеваемости наблюдается при нескольких одновременно «исповедуемых» вредных привычках – как правило, в тех случаях, когда человек курит и употребляет спиртные напитки (даже слабоалкогольные).
Изучается наследственный фактор развития описываемой патологии. Замечено, что если в семье наблюдался хотя бы один случай возникновения предастмы, это значит, что риск ее возникновения у других членов семьи возрастает.
Обратите внимание
Выявлено, что доминирующие причины возникновения данного заболевания у мужчин и женщин отличаются. Так, у представителей мужского пола предастма чаще возникает на фоне обструктивного бронхита, а женского – на фоне аллергических реакций.
Развитие патологии
Причины возникновения предастмы очень разные, поэтому и механизмы ее возникновения отличаются большим разнообразием. Тем не менее, у большинства пациентов с данным заболеванием обнаруживают хронические воспалительные изменения в слизистой оболочке бронхов.
Также у большей части пациентов выявлены аллергические реакции различного типа – от повышенной чувствительности до возникновения анафилактических реакций (резко повышенной, порой с критическими последствиями, чувствительности). В этом случае наблюдается массовое высвобождение из клеток гистамина – вещества, которое провоцирует возникновение аллергических морфологических изменений в виде отечности и повышенного образования слизи. Реагируют не только органы дыхания, но также кожные покровы, слизистые оболочки, органы пищеварительного тракта и так далее.
Обратите внимание
Усиленное образование слизи является причиной одного из наиболее критических нарушений при предастме и астме – закупорки бронхиол и возникновения удушья.
В силу развития сложных механизмов (в частности, из-за чрезмерного раздражения нервных волокон) возникает рефлекторное сужение бронхов, что усугубляет нарушение их проходимости.
В зависимости от этиологического (причинного) фактора выделены отдельные виды описываемого нарушения:
- атопический – на фоне аллергической реакции;
- инфекционно-аллергический – на фоне хронического обструктивного бронхита (в большей мере) и аллергических реакций (в меньшей мере).
Предастма — это состояние, вызывающее обеспокоенность у многих людей, особенно у тех, кто имеет предрасположенность к бронхиальной астме. Мнения о вероятности её развития варьируются. Некоторые специалисты утверждают, что наличие предастмы значительно увеличивает риск астматических проявлений, особенно при наличии аллергий или хронических респираторных заболеваний. Другие же считают, что своевременная диагностика и лечение могут существенно снизить этот риск. Многие пациенты отмечают, что соблюдение рекомендаций врачей и изменение образа жизни, включая отказ от курения и регулярные физические нагрузки, помогают контролировать симптомы и предотвращать обострения. Важно помнить, что индивидуальные факторы, такие как генетика и экология, также играют значительную роль в развитии заболевания. Поэтому каждому человеку стоит внимательно следить за своим здоровьем и консультироваться с врачом при первых признаках тревоги.

Симптомы предастмы у детей и взрослых
Клиническая картина описываемого заболевания зависит от того, какая причина привела к его возникновению. Как правило, это совокупность симптоматики со стороны различных органов и систем.
При атопической форме предастматического состояния появляются:
- признаки сезонных аллергических реакций, связанных с цветением растений – конъюнктивит (раздражение конъюнктивальной оболочки глаз со слезотечением, покраснением глаз), ринит (раздражение слизистой носа с обильны выделением слизи), крапивница (с массивным раздражением кожи);
- нарушения со стороны бронхов – выраженный кашель. Его аллергический характер подтверждается тем, что кашель возникает при контакте с аллергенами и при его прекращении, а также приеме десенсибилизирующих препаратов купируется.
При инфекционно-аллергической разновидности предастмы возникают симптомы со стороны:
- респираторной системы;
- кожных покровов и видимых слизистых оболочек.
Симптоматика со стороны респираторной системы напоминает признаки воспалительного поражения дыхательных путей, из-за чего в диагностике может возникнуть путаница. В первую очередь появляются симптомы:
- бронхита – воспаления слизистой бронхов;
- пневмонии – воспалительного поражения легочной ткани.
Это такие признаки, как:
- кашель – сильный, на начальных этапах сухой;
- отхаркивание мокроты – при прогрессировании патологии. Она слизистая, слизисто-гнойная или гнойная;
- нарушение дыхания в виде одышки – сперва при физической нагрузке, затем и в состоянии покоя.
Симптоматика со стороны кожи и слизистых напоминает таковую при поллинозах – сезонных аллергических реакциях на фоне цветения растений. В первую очередь это:
- слезотечение;
- покраснение и зуд глаз;
- выделение большого количества слизи из носа;
- нарушение носового дыхания из-за выраженного отека слизистой оболочки;
- покраснение и зуд кожных покровов.
Описанные симптомы могут возникать на протяжении от одного года до десяти лет. У некоторых пациентов они наблюдаются на протяжении всей жизни. Описываемое заболевание является одним из наиболее непрогнозируемых в медицине – фактически весь озвученный период, в течение которого проявляются признаки предастмы, является опасным в плане возникновения бронхиальной астмы, но она развивается не у всех пациентов с предастматическим синдромом. Триггером (спусковым крючком) может стать усиление влияния любых причинных факторов, которые, собственно, и привели к возникновению предастмы.
Диагностика
Диагностику описываемого заболевания проводят на основании жалоб пациента, данных анамнеза (истории) болезни, результатов дополнительных методов исследования (физикальных, инструментальных, лабораторных).
Диагноз предастмы ставят по четырем критериям – это:
- симптоматика;
- данные, указывающие на функциональные сдвиги со стороны легких – нарушение дыхательной функции при отсутствии морфологических (анатомических) изменений;
- данные, полученные при проведении лабораторных анализов;
- отягощенная наследственность – выявление предастмы у родственников пациента.
Описываемое заболевание относится к патологиям, изучение анамнеза которых – один из наиболее важных методов диагностики. В первую очередь, выясняется следующее:
- была ли диагностирована предастма в семье – в каких поколениях, с какой разницей симптоматики у них;
- отмечал ли пациент нарушения аллергического типа;
- с чем связывает пациент возникновение признаков патологии;
- наблюдается ли зависимость заболевания от сезона;
- проводилось ли лечение, было ли оно эффективно.
При физикальном обследовании выявляется следующее:
- при общем осмотре – общее состояние пациента удовлетворительное, при остром течении может ухудшаться из-за выраженного нарушения дыхания. Кожные покровы и видимые слизистые оболочки бледные, с синеватым оттенком;
- при местном осмотре – если пациент обратился к врачу на момент возникновения аллергической симптоматики, то могут отмечаться покраснение и отечность конъюнктивы, усиленное слезотечение, покраснение кожных покровов со следами расчесов;
- при пальпации (прощупывании) – нарушения со стороны легких отсутствуют;
- при перкуссии (простукивании) – со стороны легких без особенностей;
- при аускультации (прослушивании фонендоскопом) – везикулярное дыхание ослаблено, может быть жестким, выслушиваются влажные хрипы.
В первую очередь в диагностике предастмы используются следующие методы:
- рентгенография органов грудной клетки – ее проводят с целью дифференциальной диагностики с нарушениями со стороны легких, возникшими по другим причинам. При предастме на рентгенологических снимках изменения часто не обнаруживают, но если патология возникла на фоне обструктивного бронхита, то может быть выявлено эмфизематозное изменение легочной ткани (она словно раздутая, более воздушная);
- бронхоскопия – в просвет бронхов вводят бронхоскоп (разновидность эндоскопического оборудования), обнаруживают повышенное количество слизи, сужение бронхов, покраснение их слизистой оболочки;
- бронхография – под общим обезболиванием в просвет бронхов вводят контрастное вещество, после чего делают рентгенологические снимки. Метод проводится для дифференциальной диагностики – в первую очередь, для выявления возможной деформации бронхов, которая наблюдается при ряде заболеваний;
- компьютерная томография (КТ) – ее используют для более точного изучения структуры легочной паренхимы, благодаря чему можно провести дифференциальную диагностику между патологиями, при которых страдает паренхима, и предастмой. Также привлекают усовершенствованную разновидность КТ – мультиспиральную компьютерную томографию (МСКТ);
- дыхательные тесты – больной делает серию вдохов и выдохов, задерживает дыхание, при этом объем воздуха измеряют, делают выводы про степень дыхательной недостаточности, если таковая возникла.
Также при необходимости могут привлекаться и другие методы диагностики – они направлены на выявление и оценку изменений со стороны других органов и тканей, которые могли пострадать при предастме, а также привлекаются для проведения дифференциальной диагностики. Могут быть задействованы:
- офтальмоскопия;
- осмотр носовых ходов с помощью носового зеркала;
- ларингоскопия;
- электрокардиография (ЭКГ);
- эхокардиография (ЭхоКГ)
и многие другие
Лабораторные методы, привлекаемые в изучении данной патологии, это в первую очередь:
- общий анализ крови – выявляют повышенное количество эозинофилов. Также могут быть выявлены признаки патологий, на фоне которых возникла предастма – так, при их инфекционном происхождении обнаруживают повышение количества лейкоцитов (лейкоцитоз) и СОЭ;
- бактериоскопическое исследование – в случае инфекционно-воспалительного происхождения предастмы под микроскопом исследуют мокроту, в ней идентифицируют возбудителя, выявляют в большом количестве лейкоциты и слущенные эпителиальные клетки, нередко – прожилки гноя;
- бактериологическое исследование – делают посев мокроты на питательные среды, по выросшим колониям микроорганизмов их идентифицируют;
- аллергические пробы – их привлекают для выявления аллергического агента, который мог привести к развитию предастмы. Как правило, используют скарификационные пробы (их проведение основывается на раздражении кожи скарификатором и нанесении в этом месте аллергенов).

Дифференциальная диагностика
Дифференциальную (отличительную) диагностику предастмы в первую очередь проводят с нарушениями со стороны дыхательной системы, которые манифестируются теми же признаками. Это:
- бронхит – воспаление слизистой оболочки бронхов;
- бронхиолит – воспалительное поражение слизистой оболочки бронхиол (мелких бронхов);
- пневмония – воспаление легочной ткани;
- бронхоэктатическая болезнь – выпячивания в стенке бронхов, похожие на мешочки;
- бронхиальная астма – поражение бронхов с нарушением их проходимости и приступами удушья;
- новообразования бронхов и легких – добро- и злокачественные;
- амилоидоз – образование и откладывание в тканях легкого амилоида (белково-полисахаридного комплекса, в норме в организме не синтезируемого);
- гемосидероз – скопление в легочной паренхиме природного пигмента гемосидерина;
- саркоидоз легких – образование в них плотных бугорков невоспалительного характера.
Осложнения
Чаще всего осложнениями предастмы являются:
- бронхиальная астма;
- дыхательная недостаточность – нарушение дыхательной функции легких с последующим ухудшением газообмена (поступления в них кислорода и высвобождения углекислого газа из легочной паренхимы);
- вторичные нарушения со стороны сердечно-сосудистой системы.
Лечение предастмы у детей и взрослых
Лечебные мероприятия, направленные на ликвидацию предастмы, очень разные, как как и разные ее провокаторы. Это:
- немедикаментозное лечение;
- медикаментозная терапия;
- санаторно-курортное лечение.
Назначениями немедикаментозного лечения являются:
- прекращение контакта с возможным аллергеном;
- дыхательная гимнастика.
Основные назначения немедикаментозного лечения это:
- антигистаминные препараты – для купирования аллергического компонента предастмы;
- муколитики – для облегчения отхождения мокроты;
- бронхолитики – для улучшения проходимости дыхательных путей (в частности, для расширения бронхов);
- антибактериальные препараты – при наличии инфекционного компонента предастмы;
- иммуномодуляторы – по показаниям.
Санаторно-курортное лечение проводят в профильных санаториях.
Профилактика
Основными мерами профилактики предастмы являются:
- предупреждение, выявление и купирование инфекционных, соматических, иммунных и гормональных заболеваний;
- предупреждение влияния на организм климатических, бытовых и профессиональных факторов, которые могут спровоцировать развитие описываемого заболевания;
- отказ от вредных привычек;
- общее укрепление организма, поддержание его гомеостаза (основных параметров внутренней среды) благодаря таким рекомендациям, как соблюдение режима труда, отдыха, сна, рациональное питание, занятия физкультурой;
- регулярное прохождение профилактических осмотров у пульмонолога даже при отсутствии каких-либо жалоб.
Прогноз
Прогноз при предастме разный – в зависимости от причины, которая спровоцировала ее развитие, длительности влияния патологических факторов и самого заболевания. Но для жизни прогноз на этапе развития предастмы в целом благоприятный – критических последствий не наблюдается. У каждого десятого пациента с предастмой (в некоторых регионах у каждого пятого) бронхиальная астма возникает на фоне описываемого нарушения даже при его лечении. Почему так происходит – на данный момент выясняется.
Прогноз улучшается в таких случаях, как:
- иммунопрофилактика;
- раннее выявление патологии и ее адекватное лечение.
Прогноз ухудшается в таких случаях, как:
- длительное время течения патологии;
- сопутствующие заболевания и патологические состояния со стороны органов дыхания;
- продолжающееся воздействие на организм человека провоцирующих факторов.
Ковтонюк Оксана Владимировна, медицинский обозреватель, хирург, врач-консультант
Вопрос-ответ
Можно ли предотвратить развитие астмы?
Для профилактики бронхиальной астме необходимо соблюдение следующих рекомендаций: прогулки на свежем воздухе не менее 2 часов в день, исключение контактов с аллергеном (например, домашними животными, табачным дымом, резкими запахами),
Что может спровоцировать появление астмы?
К наиболее агрессивным возбудителям бронхиальной астмы относятся домашняя пыль, грибок, клещ, пыльца цветов, растений и деревьев, пух и шерсть животных, тараканы, некоторые продукты питания. Выяснить, насколько влияет на астматика тот или иной аллерген, возможно при помощи аллергопроб, проводимых в лабораториях.
Может ли у вас просто развиться астма?
Астма — это распространенное заболевание легких, которое иногда вызывает затруднения дыхания. Она поражает людей всех возрастов и часто начинается в детстве, хотя может впервые проявиться и у взрослых .
Как быстро развивается бронхиальная астма?
Приступы у пациента развиваются обычно не чаще 1 раза в неделю в дневное время суток и не чаще 2 раз в ночное Вторая ступень. Симптомы бронхиальной астмы проявляются у пациентов не ежедневно, но каждую неделю. Обычно они развиваются в ночное время, от 4 и более раз в месяц
Советы
СОВЕТ №1
Регулярно проходите медицинские обследования, особенно если у вас есть предрасположенность к аллергиям или респираторным заболеваниям. Раннее выявление симптомов может помочь предотвратить развитие бронхиальной астмы.
СОВЕТ №2
Обратите внимание на свое окружение. Устранение аллергенов в доме, таких как пыль, шерсть животных и плесень, может значительно снизить риск развития астмы. Используйте очистители воздуха и регулярно проводите уборку.
СОВЕТ №3
Следите за своим образом жизни: занимайтесь спортом, правильно питайтесь и избегайте курения. Здоровый образ жизни укрепляет иммунную систему и может помочь снизить вероятность возникновения бронхиальной астмы.
СОВЕТ №4
Обучитесь управлению стрессом, так как эмоциональное напряжение может усугубить симптомы астмы. Практикуйте методы релаксации, такие как медитация или йога, чтобы поддерживать психоэмоциональное здоровье.